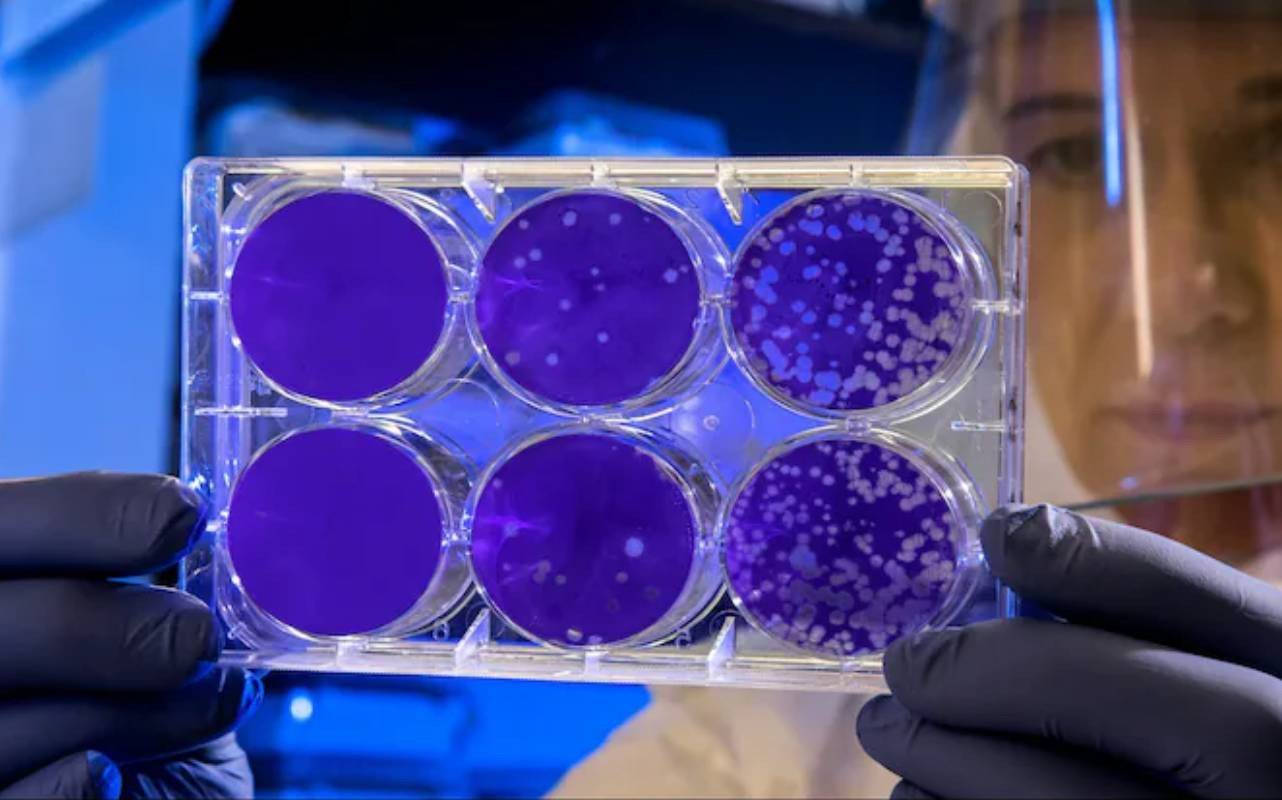
‘মৃত্যুর ভান’ করে বেঁচে থাকা ব্যাকটেরিয়া নিয়ে নতুন সতর্কবার্তা

পৃথিবীর সবচেয়ে পরিষ্কার পরিবেশেও এক ধরনের বিরল ব্যাকটেরিয়া বেঁচে থাকে নিজেদের ‘মৃত’ ভান করে। সম্প্রতি এমনই তথ্য দিয়েছে যুক্তরাষ্ট্রের ইউনিভার্সিটি অব হিউস্টনের গবেষকরা। এই ব্যাকটেরিয়ার নাম টারসিকক্কাস ফিনিকিস (Tersicoccus phoenicis)।
গবেষকেরা বলছেন, ব্যাকটেরিয়াটি এমনভাবে নিজের জীবনপ্রক্রিয়া বা বিপাকক্রিয়া (metabolism) প্রায় পুরোপুরি বন্ধ করে দিতে পারে যে, সাধারণ জীবাণুনাশক পরীক্ষা বা স্টেরিলাইজেশনেও তা ধরা পড়ে না।
ব্যাকটেরিয়াটি প্রথম পাওয়া যায় এক দশকের বেশি আগে ফ্লোরিডা ও ফরাসি গায়ানার স্পেসক্রাফট তৈরি হওয়ার আল্ট্রা-ক্লিন রুমে। এসব ঘরে সামান্য ধূলিকণাও সাধারণত থাকে না। তবুও এই জীবাণু টিকে থাকে এবং চাইলে দীর্ঘ সময় নিষ্ক্রিয় অবস্থায় পড়ে থাকে।
গবেষকেরা বলছেন, এটি পানিশূন্যতা, খাদ্য–স্বল্পতা এবং জীবাণুনাশক স্প্রে—সবকিছুই সহ্য করতে পারে। সঠিক প্রোটিন পেলে আবার ধীরে ধীরে ‘জেগে ওঠে’ এবং স্বাভাবিকভাবে সক্রিয় হয়।
গবেষক নিলস অ্যাভারেশ বলেন, কিছু জীবাণু খুবই কম মাত্রার বিপাকীয় স্তরে যেতে পারে, যা তাদের এমন পরিবেশেও বাঁচিয়ে রাখে যেখানে অন্য জীবাণু টিকে থাকতে পারে না। তার মতে, এই ব্যাকটেরিয়া যদি ইচ্ছাকৃতভাবে নিজের বিপাক বন্ধ রাখতে পারে, তবে মহাকাশযানের বাইরের অংশে বা গভীর মহাকাশ ভ্রমণের সময়ও এর টিকে থাকার সম্ভাবনা রয়েছে।
গবেষকেরা আরও জানান, ব্যাকটেরিয়াটি স্পোর তৈরি করে না। সাধারণত স্পোরধারী জীবাণুর টিকে থাকার ক্ষমতা বেশি হয়। কিন্তু এই ব্যাকটেরিয়া স্পোর ছাড়াই এত শক্তভাবে বাঁচতে পারায় বিজ্ঞানীরা মনে করছেন, পৃথিবীর জীবাণুর মধ্যে আরও কিছু অজানা টিকে থাকার কৌশল লুকিয়ে থাকতে পারে।
এই আবিষ্কার মহাকাশ গবেষণায় নতুন প্রশ্ন তুলেছে—বিশেষ করে অন্য গ্রহে মিশন পাঠানোর সময় অনিচ্ছাকৃত জীবাণু ছড়িয়ে পড়া ঠেকানো কতটা কঠিন হতে পারে।
বিডিপ্রতিদিন/কবিরুল